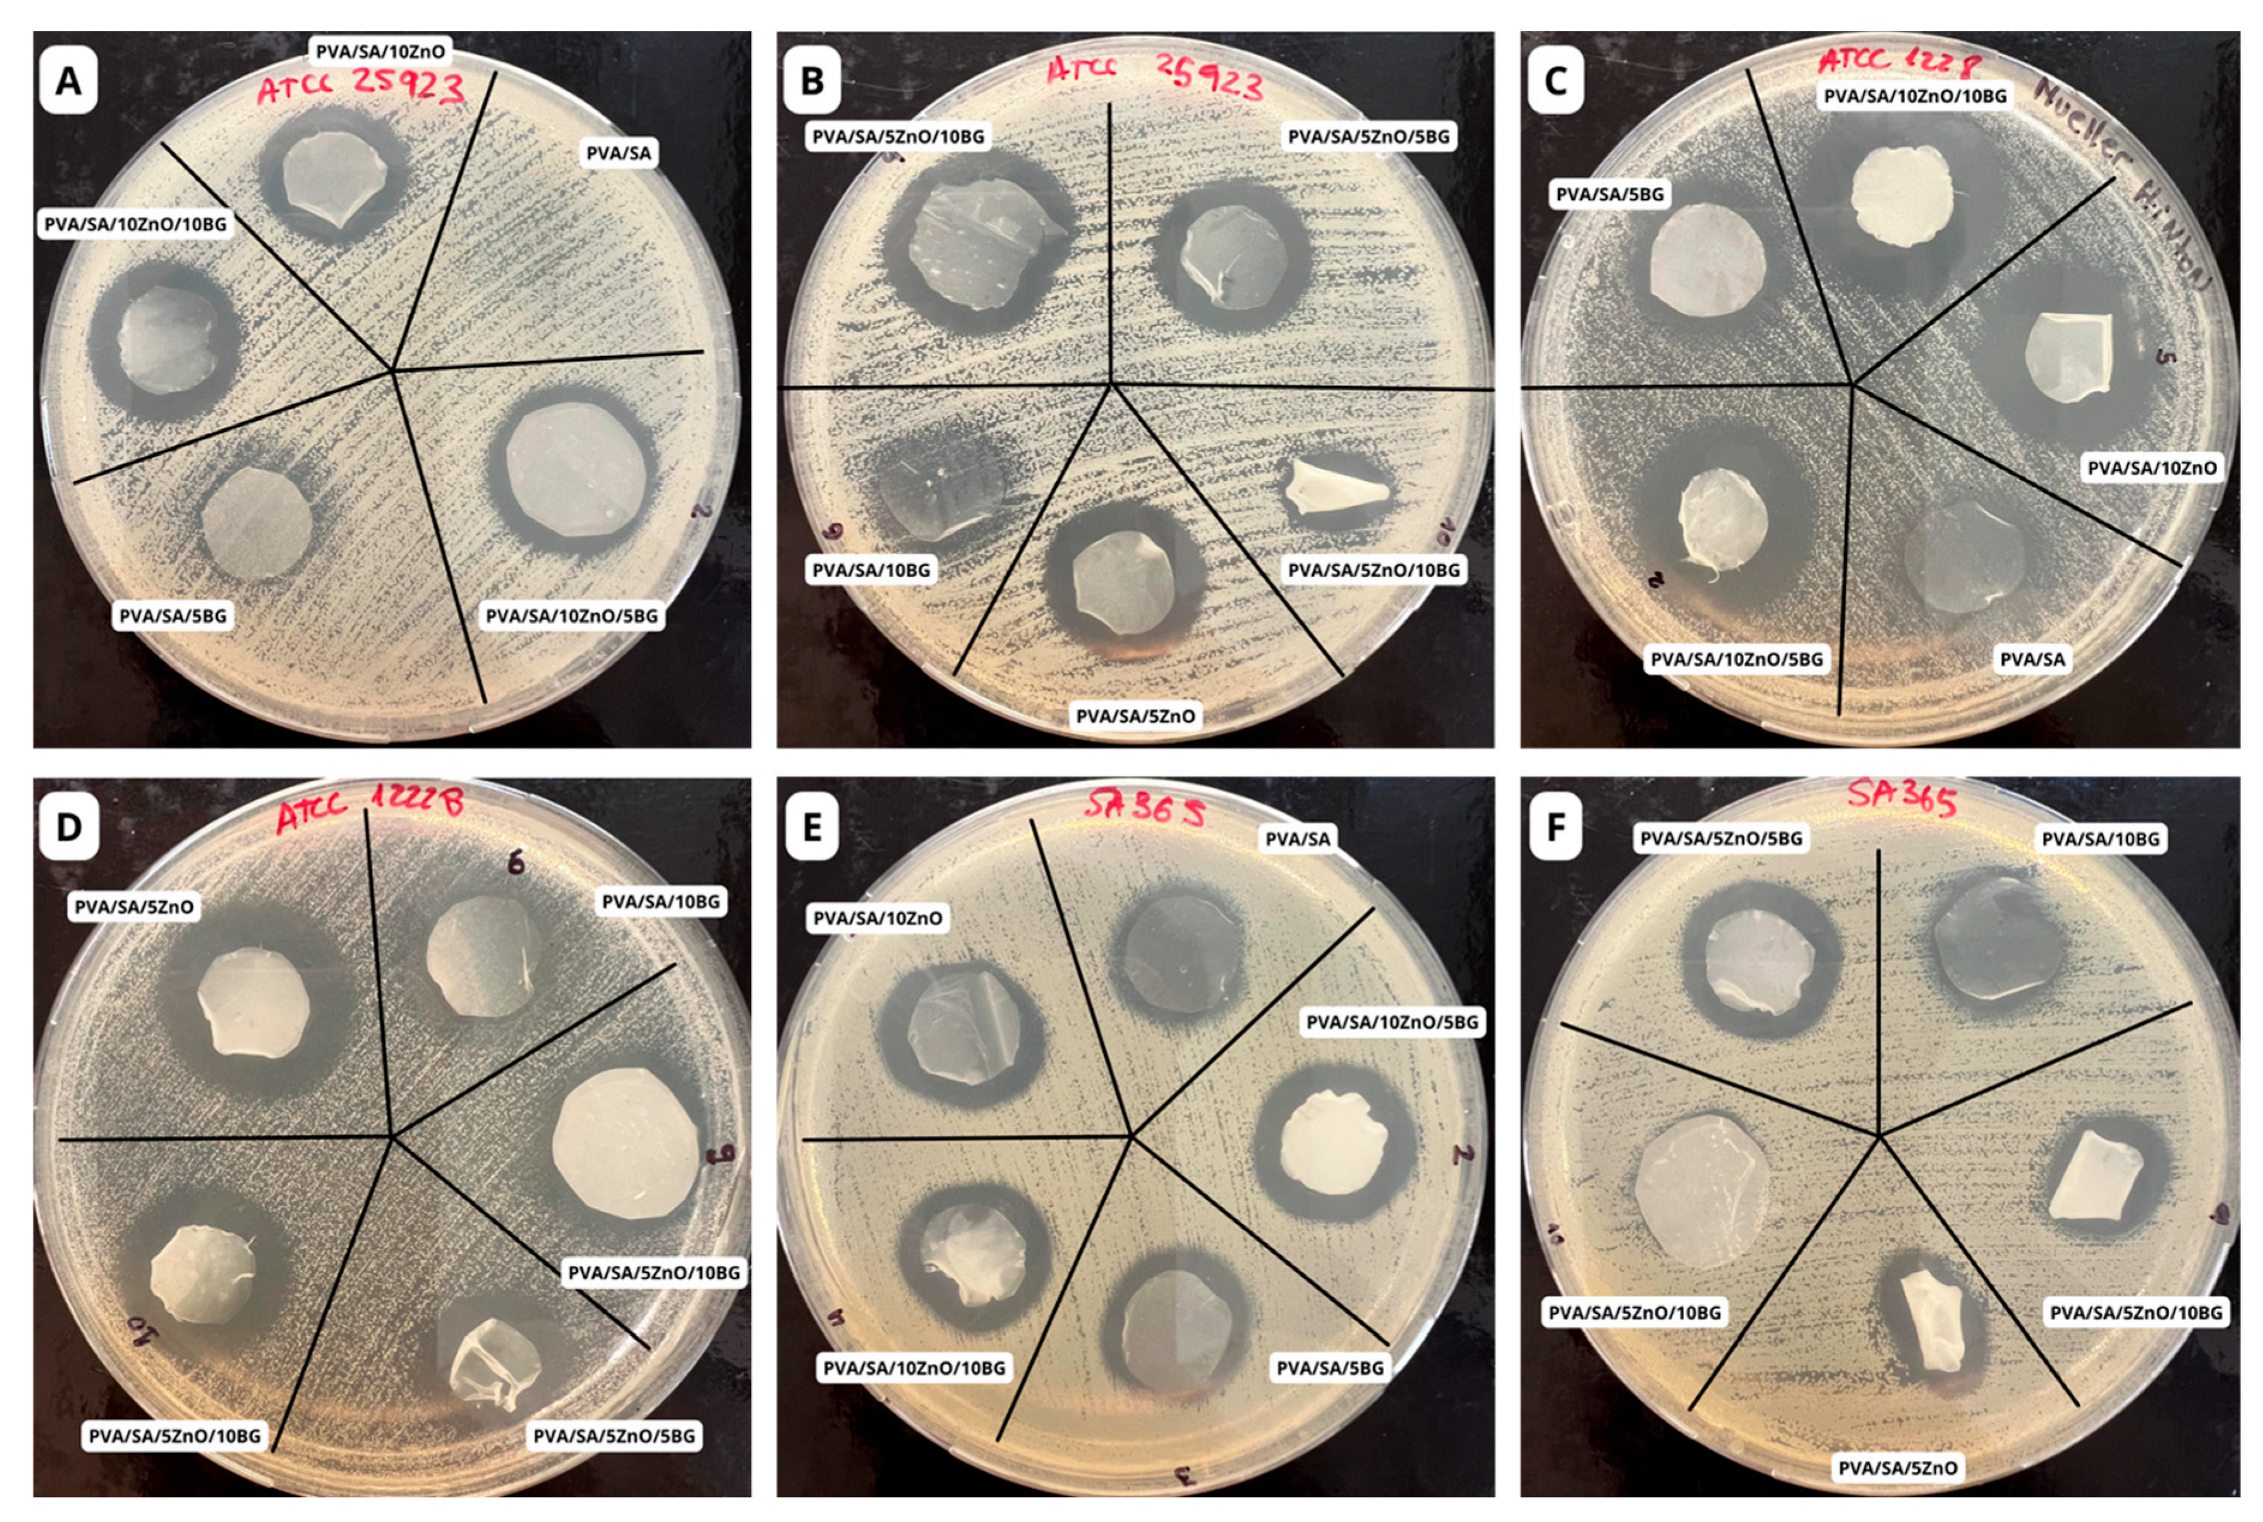
Polymers 17 02185 g009

Electrospun Polyvinyl Alcohol/Sodium Alginate Nanocomposite Dressings Loaded with ZnO and Bioglass: Characterization, Antibacterial Activity, and Cytocompatibility
Abstract
1. Introduction
2. Materials and Methods
2.1. Materials
2.2. Synthesis of Ternary Bioglass (BG) Nanoparticles
2.3. Synthesis of ZnO Nanoparticles
2.4. Preparation of PVA/SA with ZnO and BG Nanoparticles Blend Solutions
2.5. Electrospinning of PVA/SA/ZnO/BG Blend Nanofibers
2.6. Characterization
2.6.1. ZnO and BG Nanoparticles
2.6.2. PVA/SA/ZnO/BG/ Nanofibers
2.6.3. Mechanical Properties
2.7. In Vitro Antibacterial Evaluation
2.8. In Vitro Cytotoxicity Evaluation
2.9. Statistical Analysis
3. Results and Discussion
3.1. ZnO and Bioglass Nanoparticles Characterization
3.2. Preparation and Morphology of PVA/SA Nanofibers with ZnO and BG Nanoparticles
3.3. Characterization of PVA/SA Nanofibers with ZnO and BG Nanoparticles
3.3.1. ATR-FTIR Spectroscopic and XRD Characterization
3.3.2. Thermal Properties
3.3.3. Mechanical Properties
3.4. In Vitro Antibacterial Evaluation
3.5. In Vitro Cell Viability and Cytotoxicity Evaluation
4. Conclusions
Supplementary Materials
Author Contributions
Funding
Institutional Review Board Statement
Data Availability Statement
Conflicts of Interest
References
- Shariatzadeh, F.J.; Currie, S.; Logsetty, S.; Spiwak, R.; Liu, S. Enhancing wound healing and minimizing scarring: A comprehensive review of nanofiber technology in wound dressings. Prog. Mater. Sci. 2025, 147, 101350. [Google Scholar] [CrossRef]
- Palani, N.; Vijayakumar, P.; Monisha, P.; Ayyadurai, S.; Rajadesingu, S. Electrospun nanofibers synthesized from polymers incorporated with bioactive compounds for wound healing. J. Nanobiotechnol. 2024, 22, 1–30. [Google Scholar] [CrossRef] [PubMed]
- Cheriyan, S.; Shin, H.; Razack, S.A.; Kang, M.; Boopathi, T.S.; Kang, H.W.; Mani, K. In-vitro and in-vivo studies of tridax procumbens leaf extract incorporated bilayer polycaprolactone/polyvinyl alcohol-chitosan electrospun nanofiber for wound dressing application. Int. J. Biol. Macromol. 2025, 299, 139920. [Google Scholar] [CrossRef]
- Yan, S.; Qian, Y.; Haghayegh, M.; Xia, Y.; Yang, S.; Cao, R.; Zhu, M. Electrospun organic/inorganic hybrid nanofibers for accelerating wound healing: A review. J. Mater. Chem. B 2024, 12, 3171–3190. [Google Scholar] [CrossRef]
- Yang, X.; Wang, B.; Sha, D.; Liu, Y.; Liu, Z.; Shi, K.; Liu, W.; Yu, C.; Ji, X. PVA/Poly(hexamethylene guanidine)/gallic acid composite hydrogel films and their antibacterial performance. ACS Appl. Polym. Mater. 2021, 3, 3867–3877. [Google Scholar] [CrossRef]
- Chen, Y.; Bera, H.; Si, L.; Xiu, F.; Liu, P.; Li, J.; Xu, X.; Zhu, X.; Li, Y.; Cun, D.; et al. Tailor-made curdlan based nanofibrous dressings enable diabetic wound healing. Carbohydr. Polym. 2025, 348, 122876. [Google Scholar] [CrossRef] [PubMed]
- Mokhena, T.C.; Mochane, M.J.; Mtibe, A.; John, M.J.; Sadiku, E.R.; Sefadi, J.S. Electrospun alginate nanofibers toward various applications: A review. Materials 2020, 13, 934. [Google Scholar] [CrossRef]
- Kenawy, E.R.; Kamoun, E.A.; Shehata, A.; El-Moslamy, S.H.; Abdel-Rahman, A.A.H. Biosynthesized ZnO nps load-ed-electrospun PVA/sodium alginate/glycine nanofibers: Synthesis, spinning optimization and antimicrobial activity evaluation. Sci. Rep. 2025, 15, 1882. [Google Scholar] [CrossRef] [PubMed]
- Zhan, Y.; Sun, H.; Zhang, Z.; Chen, X.; Xu, Z.; He, Y.; Tao, S.; Fan, L.; Tan, J. Chitosan and polyvinyl alcohol-based bilayer electrospun nanofibrous membrane incorporated with astaxanthin promotes diabetic wound healing by addressing multiple factors. Int. J. Biol. Macromol. 2025, 311, 143921. [Google Scholar] [CrossRef]
- Deng, Y.; Yao, H.; Zhao, J.; Wei, J. Immunomodulatory and osteogenic effects of chitosan-based injectable hydrogel with geniposide-loaded mesoporous bioactive glass. Int. J. Biol. Macromol. 2025, 284, 138050. [Google Scholar] [CrossRef] [PubMed]
- Mehrabi, T.; Mesgar, A.S.; Mohammadi, Z. Bioactive glasses as biologically active materials for healing of skin wounds. Bioact. Glas. Glass-Ceram. Fundam. Appl. 2022, 519–536. [Google Scholar] [CrossRef]
- Temel-Soylu, T.M.; Keçeciler-Emir, C.; Rababah, T.; Özel, C.; Yücel, S.; Basaran-Elalmis, Y.; Altan, D.; Kirgiz, Ö.; Seçinti, İ.E.; Kaya, U.; et al. Green electrospun poly(vinyl alcohol)/gelatin-based nanofibrous membrane by incorporating 45S5 bioglass nanoparticles and urea for wound dressing applications: Characterization and in vitro and in vivo evaluations. ACS Omega 2024, 9, 21187–21203. [Google Scholar] [CrossRef]
- Zhang, P.; Jiang, Y.; Liu, D.; Liu, Y.; Ke, Q.; Xu, H. A bioglass sustained-release scaffold with ecm-like structure for enhanced diabetic wound healing. Nanomedicine 2020, 15, 2241–2253. [Google Scholar] [CrossRef]
- Pino, P.; Bosco, F.; Mollea, C.; Onida, B. Antimicrobial nano-Zinc Oxide biocomposites for wound healing applications: A review. Pharmaceutics 2023, 15, 970. [Google Scholar] [CrossRef]
- Garcia, M.M.; Da Silva, B.L.; Sorrechia, R.; Pietro, R.C.L.R.; Chiavacci, L.A. Sustainable antibacterial activity of polyamide fabrics containing ZnO nanoparticles. ACS Appl. Bio. Mater. 2022, 5, 3667–3677. [Google Scholar] [CrossRef] [PubMed]
- Kononenko, V.; Repar, N.; Marušič, N.; Drašler, B.; Romih, T.; Hočevar, S.; Drobne, D. Comparative in vitro genotoxicity study of ZnO nanoparticles, ZnO macroparticles and ZnCl2 to MDCK kidney cells: Size matters. Toxicol. Vitr. 2017, 40, 256–263. [Google Scholar] [CrossRef]
- Larijani, G.; Parivar, K.; Hayati Roodbari, N.; Yaghmaei, P.; Amini, N. Fortified electrospun collagen utilizing biocompatible poly glycerol sebacate prepolymer (PGSp) and Zink Oxide nanoparticles (ZnO NPs) for diabetics wound healing: Physical, biological and animal studies. Regen. Ther. 2024, 26, 102–113. [Google Scholar] [CrossRef]
- Mutalik, C.; Nivedita; Sneka, C.; Krisnawati, D.I.; Yougbaré, S.; Hsu, C.C.; Kuo, T.R. Zebrafish insights into nanomaterial toxicity: A focused exploration on metallic, metal oxide, semiconductor, and mixed-metal nanoparticles. Int. J. Mol. Sci. 2024, 25, 1926. [Google Scholar] [CrossRef]
- Motelica, L.; Ficai, D.; Petrisor, G.; Oprea, O.-C.; Trușcǎ, R.-D.; Ficai, A.; Andronescu, E.; Hudita, A.; Holban, A.M. Antimicrobial hydroxyethyl-cellulose-based composite films with zinc oxide and mesoporous silica loaded with cinnamon essential oil. Pharmaceutics 2024, 16, 1225. [Google Scholar] [CrossRef] [PubMed]
- Zhang, Y.; Nayak, T.R.; Hong, H.; Cai, W. Biomedical applications of Zinc Oxide nanomaterials. Curr. Mol. Med. 2013, 13, 1633–1645. [Google Scholar] [CrossRef] [PubMed]
- Moradi, S.; Nazarian, S.; Milan, P.B.; Nilforoushzadeh, M.A.; Zargan, J. Silk fibroin based core-shell nanofibers loaded with ZnO nanoparticles: An Ideal Candidate for Designing a Medicated Wound Dressing. J. Med. Biol. Eng. 2023, 43, 689–705. [Google Scholar] [CrossRef]
- Rezaei, A.; Katoueizadeh, E.; Zebarjad, S.M. Investigating of the Influence of Zinc Oxide nanoparticles morphology on the properties of electrospun polyvinyl alcohol/chitosan (PVA/CS) nanofibers. J. Drug. Deliv. Sci. Technol. 2023, 86, 104712. [Google Scholar] [CrossRef]
- Li, Y.; Sun, L.; Webster, T.J. The investigation of ZnO/Poly(Vinylidene Fluoride) nanocomposites with improved mechanical, piezoelectric, and antimicrobial properties for orthopedic applications. J. Biomed. Nanotechnol. 2018, 14, 536–545. [Google Scholar] [CrossRef]
- Canales, D.A.; Piñones, N.; Saavedra, M.; Loyo, C.; Palza, H.; Peponi, L.; Leonés, A.; Baier, R.V.; Boccaccini, A.R.; Grünelwald, A.; et al. Fabrication and assessment of bifunctional electrospun Poly(L-Lactic acid) scaffolds with bioglass and Zinc Oxide nanoparticles for bone tissue engineering. Int. J. Biol. Macromol. 2023, 228, 78–88. [Google Scholar] [CrossRef] [PubMed]
- Ramar, G.; Bensingh, R.J.; Bhuvana, K.P. Enhancing bioactivity of nanofibrous Poly(Caprolactone)/45S5 bioglass composite scaffolds by incorporation of Ag, GO, and ZnO nanoparticles. ACS Biomater. Sci. Eng. 2023, 9, 6186–6197. [Google Scholar] [CrossRef]
- Canales, D.; Saavedra, M.; Flores, M.T.; Bejarano, J.; Ortiz, J.A.; Orihuela, P.; Alfaro, A.; Pabón, E.; Palza, H.; Zapata, P.A. Effect of bioglass nanoparticles on the properties and bioactivity of poly (lactic acid) films. J. Biomed. Mater. Res. A 2020, 108, 2032–2043. [Google Scholar] [CrossRef]
- Castro, J.I.; Araujo-Rodríguez, D.G.; Valencia-Llano, C.H.; Tenorio, D.L.; Saavedra, M.; Zapata, P.A.; Grande-Tovar, C.D. Biocompatibility assessment of polycaprolactone/polylactic acid/zinc oxide nanoparticle composites under in vivo conditions for biomedical applications. Pharmaceutics 2023, 15, 2196. [Google Scholar] [CrossRef] [PubMed]
- Mousa, M.; Dong, Y. The role of nanoparticle shapes and structures in material characterisation of Polyvinyl Alcohol (PVA) bionanocomposite films. Polymers 2020, 12, 264. [Google Scholar] [CrossRef]
- Moon, S.; Ryu, B.-Y.; Choi, J.; Jo, B.; Farris, R.J. The morphology and mechanical properties of sodium alginate based elec-trospun poly(ethylene oxide) nanofibers. Polym. Eng. Sci. 2009, 49, 52–59. [Google Scholar] [CrossRef]
- Ortiz, J.A.; Sepúlveda, F.A.; Panadero-Medianero, C.; Murgas, P.; Ahumada, M.; Palza, H.; Matsuhiro, B.; Zapata, P.A. Cyto-compatible drug delivery hydrogels based on carboxymethylagarose/chitosan PH-responsive polyelectrolyte complexes. Int. J. Biol. Macromol. 2022, 199, 96–107. [Google Scholar] [CrossRef]
- Ankita; Kumar, S.; Saralch, S.; Pathak, D. Nanopowder and thin films of ZnO by Sol Gel approach. J. Nano- Electron. Phys. 2019, 11, 04027-1-04027-5. [Google Scholar] [CrossRef]
- Sepúlveda, F.A.; Rivera, F.; Loyo, C.; Canales, D.; Moreno-Serna, V.; Benavente, R.; Rivas, L.M.; Ulloa, M.T.; Gil-Castell, O.; Ribes-Greus, A.; et al. Poly (Lactic Acid)/D-Limonene/ZnO Bio-Nanocomposites with Antimicrobial Properties. J. Appl. Polym. Sci. 2022, 139. [Google Scholar] [CrossRef]
- Bui, V.X.; Vo, M.Q.; Nguyen, T.A.; Bui, H.T. Investigation of bioactive glass-ceramic 60SiO2-30CaO-10P2O5 prepared by hydrothermal method. Adv. Mater. Sci. Eng. 2019, 2019, 1528326. [Google Scholar] [CrossRef]
- Marsalek, R. Particle Size and Zeta Potential of ZnO. APCBEE Procedia 2014, 9, 13–17. [Google Scholar] [CrossRef]
- Kesse, X.; Vichery, C.; Nedelec, J.-M. Deeper insights into a bioactive glass nanoparticle synthesis protocol to control its morphology, dispersibility, and composition. ACS Omega 2019, 4, 5768–5775. [Google Scholar] [CrossRef] [PubMed]
- Akbarpour, A.; Rahimnejad, M.; Sadeghi-Aghbash, M.; Feizi, F. Poly(vinyl alcohol) /alginate nanofibrous mats containing malva sylvestris extract: Synthesis, characterization, in vitro and in vivo assessments for burn wound applications. Int. J. Pharm. 2024, 654, 123928. [Google Scholar] [CrossRef] [PubMed]
- Wang, Y.; Ding, C.; Zhao, Y.; Zhang, J.; Ding, Q.; Zhang, S.; Wang, N.; Yang, J.; Xi, S.; Zhao, T.; et al. Sodium alginate/poly(vinyl alcohol)/taxifolin nanofiber mat promoting diabetic wound healing by modulating the inflammatory response, angio-genesis, and skin flora. Int. J. Biol. Macromol. 2023, 252, 126530. [Google Scholar] [CrossRef] [PubMed]
- Hao, D.; Swindell, H.S.; Ramasubramanian, L.; Liu, R.; Lam, K.S.; Farmer, D.L.; Wang, A. Extracellular matrix mimicking nanofibrous scaffolds modified with mesenchymal stem cell-derived extracellular vesicles for improved vascularization. Front. Bioeng. Biotechnol. 2020, 8, 633. [Google Scholar] [CrossRef]
- Izgis, H.; Ilhan, E.; Kalkandelen, C.; Celen, E.; Guncu, M.M.; Turkoglu Sasmazel, H.; Gunduz, O.; Ficai, D.; Ficai, A.; Con-stantinescu, G. Manufacturing of zinc oxide nanoparticle (ZnO NP)-loaded polyvinyl alcohol (PVA) nanostructured mats using ginger extract for tissue engineering applications. Nanomaterials 2022, 12, 3040. [Google Scholar] [CrossRef] [PubMed]
- Chien, Y.-H.; Ho, M.-T.; Feng, C.-H.; Yen, J.-H.; Chang, Y.-C.; Lai, C.-S.; Louh, R.-F. Fabrication of glutaraldehyde vapor treated PVA/SA/GO/ZnO electrospun nanofibers with high liquid absorbability for antimicrobial of staphylococcus aureus. Nanomaterials 2023, 13, 932. [Google Scholar] [CrossRef]
- Khaleel, M.R.; Hashim, F.S.; Alkhayatt, A.H.O. Preparation, characterization, and the antimicrobial activity of PVA-PVP/ZnO nanofiber films via indigenous electrospinning setup. J. Mol. Struct. 2024, 1310, 138325. [Google Scholar] [CrossRef]
- Álvarez-Carrasco, F.; Varela, P.; Sarabia-Vallejos, M.A.; García-Herrera, C.; Saavedra, M.; Zapata, P.A.; Zárate-Triviño, D.; Martínez, J.J.; Canales, D.A. Development of bioactive hybrid poly(lactic acid)/poly(methyl methacrylate) (PLA/PMMA) electrospun fibers functionalized with bioglass nanoparticles for bone tissue engineering applications. Int. J. Mol. Sci. 2024, 25, 6843. [Google Scholar] [CrossRef] [PubMed]
- Chen, Q.; Wu, J.; Liu, Y.; Li, Y.; Zhang, C.; Qi, W.; Yeung, K.W.K.; Wong, T.M.; Zhao, X.; Pan, H. Electrospun Chitosan/PVA/Bioglass nanofibrous membrane with spatially designed structure for accelerating chronic wound healing. Mater. Sci. Eng. C 2019, 105, 110083. [Google Scholar] [CrossRef] [PubMed]
- Korycka, P.; Mirek, A.; Kramek-Romanowska, K.; Grzeczkowicz, M.; Lewinska, D. Effect of electrospinning process variables on the size of polymer fibers and bead-on-string structures established with a 23 factorial design. Beilstein J. Nanotechnol. 2018, 9, 2466–2478. [Google Scholar] [CrossRef] [PubMed]
- Martínez-Gómez, F.; Guerrero, J.; Matsuhiro, B.; Pavez, J. In vitro release of metformin hydrochloride from sodium algi-nate/polyvinyl alcohol hydrogels. Carbohydr. Polym. 2017, 155, 182–191. [Google Scholar] [CrossRef]
- Cardenas-Jiron, G.; Leal, D.; Matsuhiro, B.; Osorio-Roman, I.O. Vibrational spectroscopy and density functional theory calculations of poly-d-mannuronate and heteropolymeric fractions from sodium alginate. J. Raman Spectrosc. 2011, 42, 870–878. [Google Scholar] [CrossRef]
- Jipa, I.M.; Stoica, A.; Stroescu, M.; Dobre, L.M.; Dobre, T.; Jinga, S.; Tardei, C. Potassium sorbate release from poly(vinyl alcohol)-bacterial cellulose films. Chem. Pap. 2012, 66, 138–143. [Google Scholar] [CrossRef]
- Fernández, C.A.; Martínez, C.A.; Prado, M.O.; Olmedo, D.; Ozols, A. Bone regeneration with wharton’s jel-ly-bioceramic-bioglass composite. Procedia Mater. Sci. 2015, 9, 205–212. [Google Scholar] [CrossRef][Green Version]
- Barrioni, B.R.; Norris, E.; Jones, J.R.; Pereira, M.d.M. The influence of cobalt incorporation and cobalt precursor selection on the structure and bioactivity of Sol–Gel-derived bioactive glass. J. Solgel. Sci. Technol. 2018, 88, 309–321. [Google Scholar] [CrossRef]
- Mokhena, T.C.; Luyt, A.S. Electrospun alginate nanofibres impregnated with silver nanoparticles: Preparation, morphology and antibacterial properties. Carbohydr. Polym. 2017, 165, 304–312. [Google Scholar] [CrossRef]
- Ju, T.; Gaisford, S.; Williams, G.R. Ciprofloxacin-loaded electrospun nanofibres for antibacterial wound dressings. J. Drug. Deliv. Sci. Technol. 2024, 91. [Google Scholar] [CrossRef]
- Çaykara, T.; Demirci, S. Preparation and characterization of blend films of poly(vinyl alcohol) and sodium alginate. J. Macromol. Sci. A 2006, 43, 1113–1121. [Google Scholar] [CrossRef]
- Shalumon, K.T.; Anulekha, K.H.; Nair, S.V.; Nair, S.V.; Chennazhi, K.P.; Jayakumar, R. Sodium alginate/poly(vinyl alco-hol)/nano ZnO composite nanofibers for antibacterial wound dressings. Int. J. Biol. Macromol. 2011, 49, 247–254. [Google Scholar] [CrossRef] [PubMed]
- Kim, G.-M. Fabrication of Bio-Nanocomposite Nanofibers Mimicking the Mineralized Hard Tissues via Electrospinning Process; IntechOpen: London, UK, 2010; pp. 69–88. [Google Scholar]
- Şendil, Ö.; Samatya Yilmaz, S.; Yazici Ozcelik, E.; Uzuner, H.; Aytac, A. Cross-linked electrospun polyvinyl alcohol/sodium caseinate nanofibers for antibacterial applications. J. Vinyl Addit. Technol. 2023, 29, 48–65. [Google Scholar] [CrossRef]
- Leonés, A.; Salaris, V.; Mujica-Garcia, A.; Arrieta, M.P.; Lopez, D.; Lieblich, M.; Kenny, J.M.; Peponi, L. PLA electrospun fibers reinforced with organic and inorganic nanoparticles: A comparative study. Molecules 2021, 26, 4925. [Google Scholar] [CrossRef] [PubMed]
- Rivera-Torres, F.; Maciel-Cerda, A.; González-Gómez, G.H.; Falcón-Neri, A.; Gómez-Lizárraga, K.; Esquivel-Posadas, H.T.; Vera-Graziano, R. In vitro modulation of spontaneous activity in embryonic cardiomyocytes cultured on poly(vinyl alcohol)/bioglass type 58S electrospun scaffolds. Nanomaterials 2024, 14, 372. [Google Scholar] [CrossRef]
- Rashid, T.U.; Gorga, R.E.; Krause, W.E. Mechanical properties of electrospun fibers—a critical review. Adv. Eng. Mater. 2021, 23, 2100153. [Google Scholar] [CrossRef]
- Chiu, C.T.; Lee, J.S.; Chu, C.S.; Chang, Y.P.; Wang, Y.J. Development of two alginate-based wound dressings. J. Mater. Sci. Mater. Med. 2008, 19, 2503–2513. [Google Scholar] [CrossRef]
- Gudkov, S.V.; Burmistrov, D.E.; Serov, D.A.; Rebezov, M.B.; Semenova, A.A.; Lisitsyn, A.B. A mini review of antibacterial properties of ZnO nanoparticles. Front. Phys. 2021, 9. [Google Scholar] [CrossRef]
- Augustine, R.; Malik, H.N.; Singhal, D.K.; Mukherjee, A.; Malakar, D.; Kalarikkal, N.; Thomas, S. Electrospun polycaprolactone/ZnO nanocomposite membranes as biomaterials with antibacterial and cell adhesion properties. J. Polym. Res. 2014, 21, 347. [Google Scholar] [CrossRef]
- Staphylococcus Epidermidis Infection-StatPearls-NCBI Bookshelf. Available online: https://www.ncbi.nlm.nih.gov/books/NBK563240/ (accessed on 22 August 2024).
- Almuhayawi, M.S.; Alruhaili, M.H.; Gattan, H.S.; Alharbi, M.T.; Nagshabandi, M.; Al Jaouni, S.; Selim, S.; Alanazi, A.; Alruwaili, Y.; Faried, O.A.; et al. Staphylococcus aureus induced wound infections which antimicrobial resistance, methicillin-and vancomycin-resistant: Assessment of emergence and cross sectional study. Infect. Drug. Resist. 2023, 16, 5335–5346. [Google Scholar] [CrossRef]
- Michalik, M.; Podbielska-Kubera, A.; Dmowska-Koroblewska, A. Antibiotic resistance of staphylococcus aureus strains—searching for new antimicrobial agents—review. Pharmaceuticals 2025, 18, 81. [Google Scholar] [CrossRef]
- Drago, L.; Toscano, M.; Bottagisio, M. Recent evidence on bioactive glass antimicrobial and antibiofilm activity: A mini-review. Materials 2018, 11, 326. [Google Scholar] [CrossRef] [PubMed]
- Mendes, C.R.; Dilarri, G.; Forsan, C.F.; Sapata, V.d.M.R.; Lopes, P.R.M.; de Moraes, P.B.; Montagnolli, R.N.; Ferreira, H.; Bidoia, E.D. Antibacterial action and target mechanisms of zinc oxide nanoparticles against bacterial pathogens. Sci. Rep. 2022, 12, 2658. [Google Scholar] [CrossRef] [PubMed]
- Duygulu, N.E.; Altinbay, A.; Ciftci, F. Antibacterial, mechanical, and thermal properties of Ag, ZnO, TiO2 reinforced PVA nanocomposite fibers. ChemistrySelect 2024, 9, e202402311. [Google Scholar] [CrossRef]
- Ahmed, R.; Tariq, M.; Ali, I.; Asghar, R.; Noorunnisa Khanam, P.; Augustine, R.; Hasan, A. Novel electrospun chi-tosan/polyvinyl alcohol/zinc oxide nanofibrous mats with antibacterial and antioxidant properties for diabetic wound healing. Int. J. Biol. Macromol. 2018, 120, 385–393. [Google Scholar] [CrossRef] [PubMed]
- Rajzer, I.; Dziadek, M.; Kurowska, A.; Cholewa-Kowalska, K.; Ziąbka, M.; Menaszek, E.; Douglas, T.E.L. Electrospun poly-caprolactone membranes with Zn-doped bioglass for nasal tissues treatment. J. Mater. Sci. Mater. Med. 2019, 30, 1–11. [Google Scholar] [CrossRef] [PubMed]
- Gürtler, A.L.; Rades, T.; Heinz, A. Electrospun fibers for the treatment of skin diseases. J. Control. Release 2023, 363, 621–640. [Google Scholar] [CrossRef]
- Das, P.; Mounika, P.; Yellurkar, M.L.; Prasanna, V.S.; Sarkar, S.; Velayutham, R.; Arumugam, S. Keratinocytes: An enigmatic factor in atopic dermatitis. Cells 2022, 11, 1683. [Google Scholar] [CrossRef] [PubMed]
- Ferrone, E.; Araneo, R.; Notargiacomo, A.; Pea, M.; Rinaldi, A. ZnO nanostructures and electrospun ZnO–polymeric hybrid nanomaterials in biomedical, health, and sustainability applications. Nanomaterials 2019, 9, 1449. [Google Scholar] [CrossRef]

| Designation | ZnO (wt.%) | BG (wt.%) |
|---|---|---|
| PVA/SA | 0 | 0 |
| PVA/SA/5ZnO | 5 | 0 |
| PVA/SA/10ZnO | 10 | 0 |
| PVA/SA/5BG | 0 | 5 |
| PVA/SA/10BG | 0 | 10 |
| PVA/SA/5ZnO/5BG | 5 | 5 |
| PVA/SA/5ZnO/10BG | 5 | 10 |
| PVA/SA/10ZnO/5BG | 10 | 5 |
| PVA/SA/10ZnO/10BG | 10 | 10 |
| Membrane | TG Analysis | DSC Analysis | ||||
|---|---|---|---|---|---|---|
| T10 (°C) | Tmax (°C) | Tg (°C) | Tcc (°C) | Tm (°C) | Xc (%) | |
| PVA/SA | 223 | 255 | 84 | nd | 180 | 4 |
| PVA/SA/5ZnO | 229 | 256 | 84 | nd | 172 | 2 |
| PVA/SA/10ZnO | 234 | 255 | 84 | nd | 169 | 0 |
| PVA/SA/5BG | 222 | 268 | 85 | 120 | 191 | 7 |
| PVA/SA/10BG | 229 | 270 | 84 | 130 | 198 | 10 |
| PVA/SA/5ZnO/5BG | 240 | 270 | 86 | 123 | 191 | 9 |
| PVA/SA/5ZnO/10BG | 231 | 276 | 84 | 128 | 194 | 9 |
| PVA/SA/10ZnO/5BG | 232 | 271 | 86 | 125 | 191 | 8 |
| PVA/SA/10ZnO/10BG | 251 | 272 | 84 | 133 | 194 | 8 |
Disclaimer/Publisher’s Note: The statements, opinions and data contained in all publications are solely those of the individual author(s) and contributor(s) and not of MDPI and/or the editor(s). MDPI and/or the editor(s) disclaim responsibility for any injury to people or property resulting from any ideas, methods, instructions or products referred to in the content. |
© 2025 by the authors. Licensee MDPI, Basel, Switzerland. This article is an open access article distributed under the terms and conditions of the Creative Commons Attribution (CC BY) license (https://creativecommons.org/licenses/by/4.0/).
Share and Cite
Ortiz, J.A.; Sepúlveda, F.A.; Flores, S.; Saavedra, M.; Sáez-Silva, S.; Jiménez, T.; Murgas, P.; Troncoso, S.; Sanhueza, C.; Ulloa, M.T.; et al. Electrospun Polyvinyl Alcohol/Sodium Alginate Nanocomposite Dressings Loaded with ZnO and Bioglass: Characterization, Antibacterial Activity, and Cytocompatibility. Polymers 2025, 17, 2185. https://doi.org/10.3390/polym17162185
Ortiz JA, Sepúlveda FA, Flores S, Saavedra M, Sáez-Silva S, Jiménez T, Murgas P, Troncoso S, Sanhueza C, Ulloa MT, et al. Electrospun Polyvinyl Alcohol/Sodium Alginate Nanocomposite Dressings Loaded with ZnO and Bioglass: Characterization, Antibacterial Activity, and Cytocompatibility. Polymers. 2025; 17(16):2185. https://doi.org/10.3390/polym17162185
Chicago/Turabian StyleOrtiz, J. Andrés, Francesca Antonella Sepúlveda, Siomara Flores, Marcela Saavedra, Suhelen Sáez-Silva, Thomas Jiménez, Paola Murgas, Scarlett Troncoso, Camila Sanhueza, María T. Ulloa, and et al. 2025. "Electrospun Polyvinyl Alcohol/Sodium Alginate Nanocomposite Dressings Loaded with ZnO and Bioglass: Characterization, Antibacterial Activity, and Cytocompatibility" Polymers 17, no. 16: 2185. https://doi.org/10.3390/polym17162185
APA StyleOrtiz, J. A., Sepúlveda, F. A., Flores, S., Saavedra, M., Sáez-Silva, S., Jiménez, T., Murgas, P., Troncoso, S., Sanhueza, C., Ulloa, M. T., Porte Torre, L., Ahumada, M., Corrales, T., Palza, H., & Zapata, P. A. (2025). Electrospun Polyvinyl Alcohol/Sodium Alginate Nanocomposite Dressings Loaded with ZnO and Bioglass: Characterization, Antibacterial Activity, and Cytocompatibility. Polymers, 17(16), 2185. https://doi.org/10.3390/polym17162185

